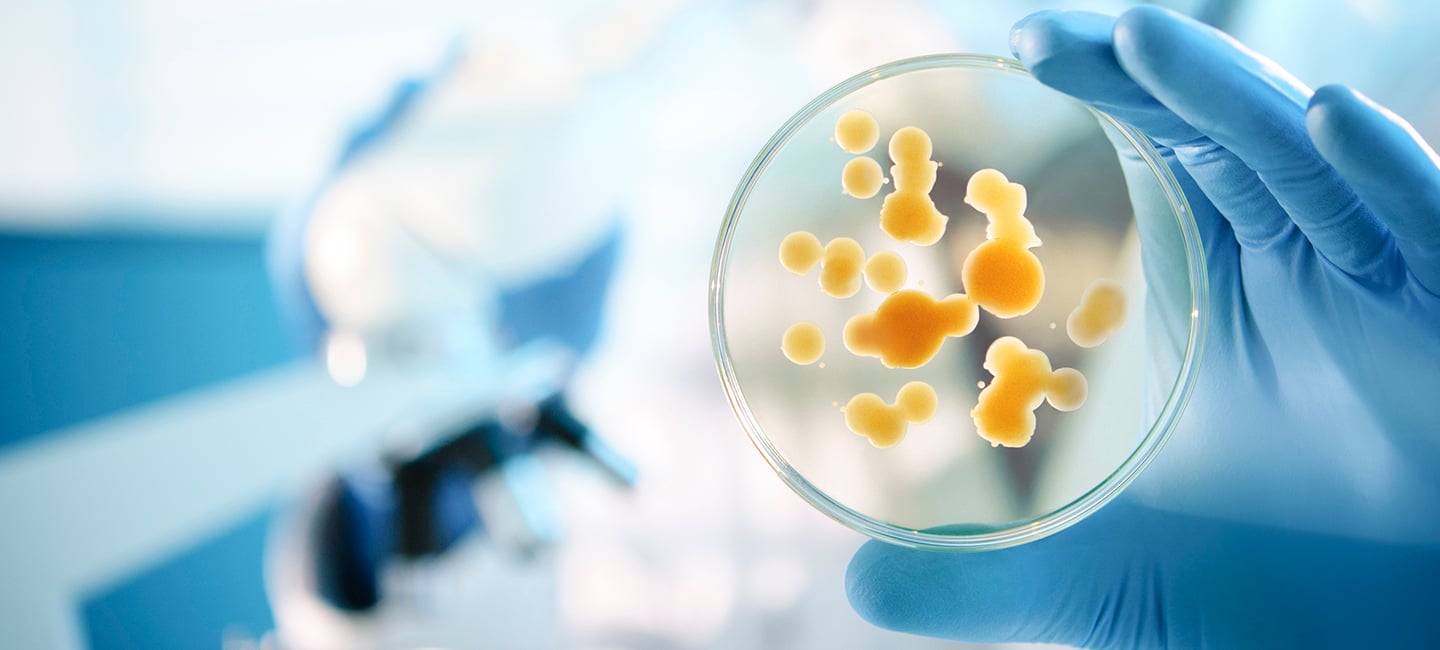

Can Fungi Drive Pancreatic Cancer?
When you think of fungus, you probably think of yeast and mushrooms. There are tens of thousands of organisms that are classified as fungi, and when it comes to your health, fungi can affect us in both positive and negative ways. It is the source of antibiotics like penicillin, but can also cause infections in the body.
A new study shows fungi may also play a role in pancreatic cancer. Researchers found fungi can make its way into the pancreas, and in both mice and humans with pancreatic cancer, the fungi can multiply 3,000-fold compared to normal pancreatic tissue.

Dr. Jennifer Permuth
“This study is intriguing because it is the first to provide some evidence that the fungal component of the pancreatic microbiome may promote changes that lead to pancreatic cancer development and progression,” said Moffitt Cancer Center researcher Dr. Jennifer Permuth. “Importantly, the findings suggest the possibility of using antifungal drugs to treat or perhaps even prevent this malignancy.”
For the study, researchers fed mice yeast with a fluorescent marker and watched as the yeast moved quickly from the digestive tract into the pancreas. They found only certain types of fungi traveled into the pancreas, most commonly a type of fungus called Malassezia, which is typically found on the skin and scalp of humans and animals and causes irritation and dandruff. Not only was Malassezia found in mice with pancreatic tumors, but also in samples from pancreatic cancer patients.
Giving the mice an antifungal drug got rid of the fungi and kept the tumors from developing.
Permuth says this study shows further research into pancreatic cancer’s microenvironment—which is made of cells that include those that regulate the immune system—is extremely important. “The results of this study provide data to support the theory that fungi may increase the risk for pancreatic cancer by triggering an inflammatory immune response that is believed to stimulate cell growth, survival, and migration—all factors that fuel cancer development and progression,” she said.
Further research on the pancreas microenvironment is needed and could offer new opportunities for early diagnosis and intervention. Almost 57,000 people will be diagnosed with pancreatic cancer in the United States this year, but only about 9% will survive after five years.
“We are desperately in need of prevention and early detection strategies for pancreatic cancer, and the microenvironment may be a promising new target for therapeutic drugs and an important area for discovering biomarkers,” said Permuth. “If certain anti-fungal medications could be safely provided to humans at risk for pancreatic cancer, there could be significant opportunities to reduce disease burden in this population.”
Permuth added that further research would be needed before antifungal agents, many of which have serious side effects, are incorporated into pancreatic cancer treatment regimens.